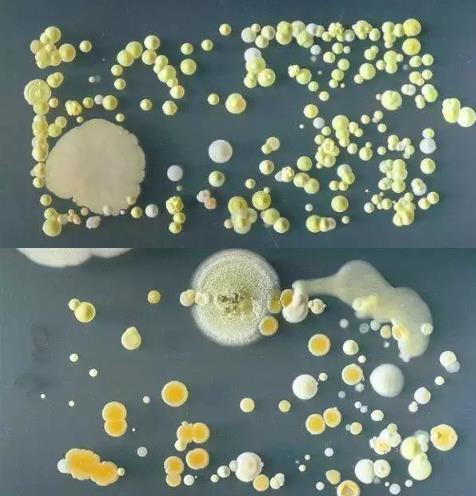
手机镜头竟能照出马桶上的脏东西:快试试(图) 手机镜头竟能照出马桶上的脏东西:快试试(图)
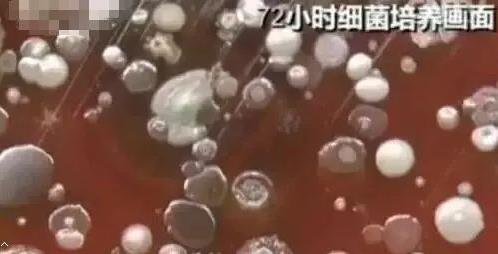
手机镜头竟能照出马桶上的脏东西:快试试(图) 手机镜头竟能照出马桶上的脏东西:快试试(图)
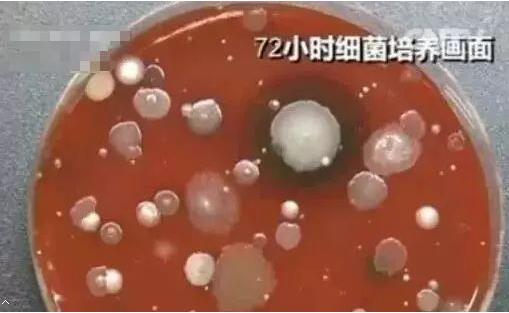
手机镜头竟能照出马桶上的脏东西:快试试(图) 手机镜头竟能照出马桶上的脏东西:快试试(图)
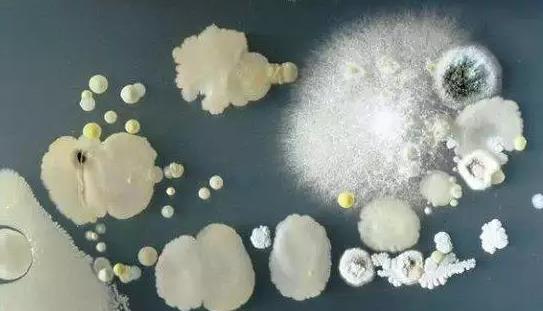
手机镜头竟能照出马桶上的脏东西:快试试(图) 手机镜头竟能照出马桶上的脏东西:快试试(图)

手机镜头竟能照出马桶上的脏东西:快试试(图)
你的手机真的比马桶还脏吗?
看小编给你辟谣

这是真的吗?
其实
并没有这里说的那么可怕
基本可以认定为
又是一则谣言
△据称这是一位经常用酒精擦拭手机的出租汽车司机的手机细菌情况。
△据称这是手机很脏的细菌情况。
真相 手机可能传播疾病吗?
基本不会。虽然手机会携带不同数量和种类的致病微生物。
在细菌家族里,真正的致病菌只占很小的一部分,大部分的细菌可以和人和平共处。
“比马桶还脏”的东西如果是单纯的“细菌数量比马桶多”,是没有意义的,必须要对比双方细菌的种类,看看哪个致病菌多才可以。没有任何科学研究表明,手机上的致病微生物会给使用者带来严重的健康风险。